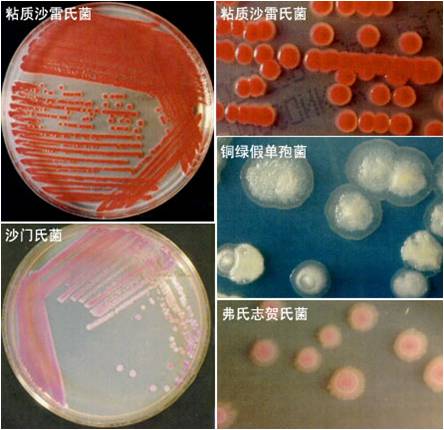

细菌(四)
-
1 内容
-
2 练习
上一节
下一节
内容
细菌的繁殖与培养特征
● 细菌繁殖
裂殖:二分裂、三分裂、复分裂

芽殖:母细胞表面先形成一个小突起,待其长大到与母细胞相仿后再相互分离并独立生活的一种繁殖方式,凡以这类方式繁殖的细菌,统称为芽生细菌。
● 菌落特征
固体培养基的(内)的群体形态:
菌落:
在固体培养其上(内)以母细胞为中心的一堆肉眼可见的,有一定形态、构造等特征的子细胞集团。如果菌落由一个单细胞形成的,则它就是一个纯种细胞群或克隆。
菌苔:
大量分散的纯种细胞密集地接种在固体培养基的较大表面上,结果长出的大量“菌落已相互连成一片,这就是菌苔。
细菌的菌落特征:
一般呈现湿润、较光滑、较透明、较粘稠、易挑取、质地均匀以及菌落正反面或边缘与中央部位颜色一致等。其原因是细菌属间细胞生物,一个菌落内无数细胞并没有形态和功能上的分化,细胞间充满着毛细管状态的水,等等。
半固体培养基上(内)的群体形态:
在半固体培养基直立柱表面和穿刺线上细菌群体的生长状态和有否扩散现象可判断该菌的运动能力和其他特征。
液体培养基上(内)的群体形态:
细菌在液体培养基中生长时,会因其细胞特征、比重、运动能力和对氧气等关系的不同,而形成几种不同的群体形态:多数表现为混浊,部分表现为沉淀,一些好氧性细菌则在液面上大量生长,形成有特征性的、厚薄有差异的菌醭、菌膜或环状、小片装不连续的菌膜等。

